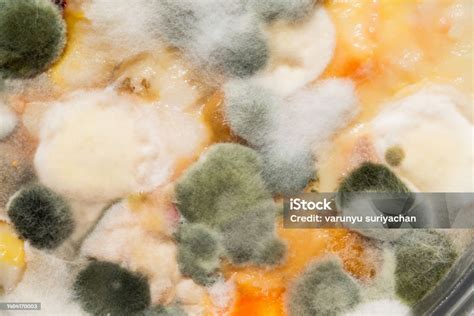
jamur closeup makanan kotor bakteri foto stok  gambar

Jika kamu sedang mencari Makanan Yang Kotor, maka anda berada di halaman yang tepat. Kami menyediakan aneka Makanan Yang Kotor yang bisa anda pesan online. Silakan hubungi kami via +6282245078486, jangan lupa sertakan juka gambar yang diinginkan.
Kami mengirim paket Makanan Yang Kotor melalui berbagai ekspedisi, misalnya JNE, JNT, POS, dll. Kami juga menerima pembayaran via BCA/Mandiri/dll. Pengiriman biasanya tidak sampai seminggu sudah sampai dan kami sertakan pula nomor resi yang bisa digunakan untuk tracking barang secara online.

Tidak hanya Makanan Yang Kotor, anda juga bisa melihat gambar lain seperti
Fast Food,
Hari Raya,
Contoh Spanduk,
Jawa Tengah,
Nasi Lemak,
Model Palembang,
Mie Goreng,
Hitam Putih,
Kaum Di Malaysia,
Contoh Brosur,
Mie Ayam,
Nasi Padang,
Sedap Malam,
Suku Bali,
Khas Riau,
Thai,
Manis,
PNG,
Indonesia,
Khas Sumatera,
Menu,
Di Sabah,
Sunda,
Western,
Makanan Kotor,
Makanan Usus,
Makanan Yang Bersih,
Makanan Jijik,
Makanan Bergoreng,
Contoh Makanan Kotor,
Makanan Lebaran,
Gerai Makanan Kotor,
and Restoran Yang Kotor.
Berbagai Contoh Makanan Yang Kotor
Berikut kami sertakan berbagai contoh gambar untuk Makanan Yang Kotor, silakan save gambar di bawah dengan klik tombol pesan, anda akan kami arahkan pemesanan via WA ke +6282245078486.
 1600×1135
1600×1135
gambar kelas kotor sains anak gambar gambar kartun
Order Sekarang
 683×1024
683×1024
hindari makanan membuat usus kotor nusa berita
Order Sekarang
 590×400
590×400
sembilan premis makanan kotor diarah tutup astro awani
Order Sekarang
 640×426
640×426
benarkah piring kotor dapur semalaman jadi makanan setan
Order Sekarang
 479×359
479×359
piring kotor sendok kotor diisi sisa makanan tisu bekas
Order Sekarang
 1280×958
1280×958
tular rumah peniaga makanan kotor kosmo digital
Order Sekarang
1024×683
1024×683
jamur closeup makanan kotor bakteri foto stok gambar
Order Sekarang
 800×450
800×450
sisi gelap industri makanan cepat saji industri kotor
Order Sekarang
 1200×628
1200×628
didapati terlalu kotor tiga premis makanan bintulu diarahkan tutup
Order Sekarang
 3334×2964
3334×2964
desain kemasan produk makanan menarik rak supermarket gondola
Order Sekarang
 1920×1080
1920×1080
produk makanan kotor skandal keamanan pangan tiongkok truth media
Order Sekarang
 1080×810
1080×810
premis makanan kotor kompaun dikeluarkan edisi
Order Sekarang
 1280×720
1280×720
kotor memualkan premis makanan diarah tutup kosmo digital
Order Sekarang
 1200×630
1200×630
tiga kilang makanan kotor diarah tutup merta harian metro
Order Sekarang
 1024×683
1024×683
sisa makanan piring kotor setelah salad selesai foto stok
Order Sekarang
 590×400
590×400
premis makanan kotor seremban diarah tutup dua minggu astro awani
Order Sekarang
 612×408
612×408
wastafel cuci kotor sisa makanan limbah foto stok
Order Sekarang
 510×339
510×339
makanan kotor atas hidangan putih setelah makan foto stok
Order Sekarang
 603×439
603×439
dbkl kompaun premis makanan kotor jijik berbau busuk mykmunet
Order Sekarang
 660×460
660×460
sampai pilih premis makanan kotor utusan borneo
Order Sekarang
 1024×576
1024×576
tumpukan kotak kardus kotor makanan produk kalengan
Order Sekarang
 479×359
479×359
kotak makanan pakai kotor kosong latar belakang kayu foto
Order Sekarang
 1280×720
1280×720
viral media sosial makanan india kotor tidak higenis
Order Sekarang
Temukan solusi terbaik untuk kenyamanan ruang Anda dengan Makanan Yang Kotor! Produk peredam suara dan panas ini menawarkan performa maksimal dengan harga yang terjangkau. Dapatkan kualitas unggul tanpa menguras kantong, dan nikmati suasana tenang serta sejuk di setiap sudut rumah atau kantor Anda. Pilih Makanan Yang Kotor – pilihan cerdas untuk investasi jangka panjang!
Maaf, tidak ada yang cocok dengan kriteria yang Anda cari.
Apa yang ingin Anda lakukan?
« kembali ke Beranda atau gunakan kotak pencarian dibawah ini untuk mulai penelusuran baru.










